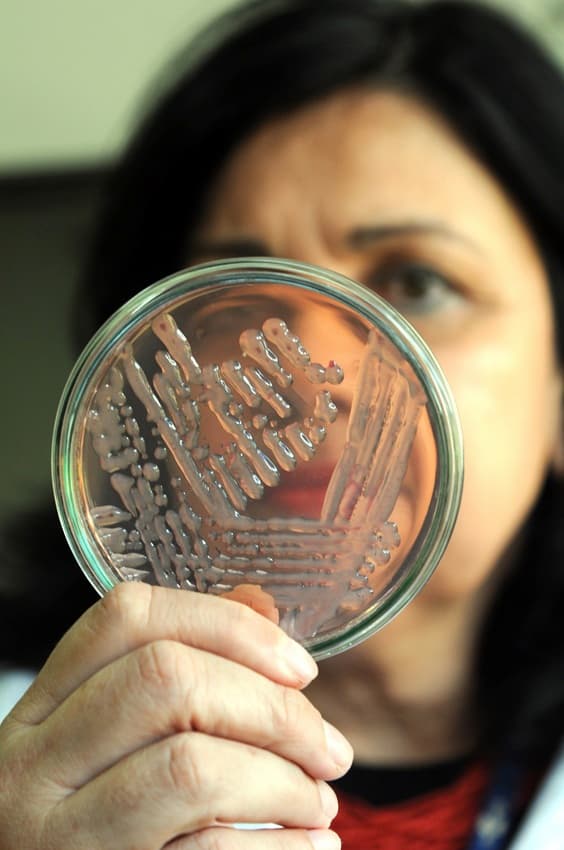
lista Time 100 Climate 2025

A pesquisadora da Embrapa Mariangela Hungria está na lista TIME100 Climate 2025 que reconhece as 100 personalidades inovadoras e mais influentes do mundo que impulsionam ações em prol de questões relacionadas ao clima ( time.com/collections/time-100-climate-2025/), na categoria Defenders (Defensores - Impulsionando ações em prol das comunidades). A lista completa (TIME100 Climate) será publicada na edição de 10 de novembro de 2025, disponível nas bancas a partir de sexta-feira, 31 de outubro. "Trabalhar com a produção de alimentos almejando a segurança alimentar usando práticas sustentáveis que permitem "defender" o planeta é um privilégio", ressalta Mariangela Hungria. "Passei a vida pesquisando sobre a substituição de químicos por biológicos na agricultura, sempre que possível. Esse reconhecimento tem um valor enorme, pois valoriza a adoção de práticas sustentáveis na agricultura", comemora a cientista.
Mariangela irá participar das ações da Embrapa na Agrizone, durante a Conferência das Nações Unidas sobre as Mudanças Climáticas de 2025 COP30, que será realizada em Belém (PA), em novembro. "Espero transmitir a mensagem sobre a viabilidade do uso de produtos biológicos para substituir agroquímicos. Com isso, mitigamos a emissão de gases de efeito estufa e também aumentamos o acesso a alimentos de qualidade", declara.
Contribuições na área de bioinsumos - Há mais de 40 anos, a pesquisadora da Embrapa Mariangela Hungria desenvolve inovações na área de microbiologia do solo, o que resultou no lançamento de mais de 30 tecnologias. O foco das suas pesquisas tem sido no aumento da produção e na qualidade de alimentos por meio da substituição, total ou parcial, de fertilizantes químicos por microrganismos portadores de propriedades como a fixação biológica de nitrogênio (FBN), a síntese de fitormônios e a solubilização de fosfatos e rochas potássicas. Mesmo em “áreas velhas”, isto é, que já receberam inoculantes antes, a inoculação anual da soja com Bradyrhizobium aumenta, em média, 8% a produção de grãos de soja. Ainda mais relevante, altos rendimentos são alcançados sem nenhuma aplicação de fertilizante nitrogenado. A tecnologia é adotada em 85% da área cultivada com soja no Basil.
Outra tecnologia lançada pela pesquisadora foi a da coinoculação da soja, que agrega bactérias fixadoras de nitrogênio (Bradyrhizobium) e bactérias promotoras de crescimento de plantas (Azospirillum brasilense). Em pouco mais de 10 anos, a coinoculação já é adotada em aproximadamente 35% da área total cultivada de soja. Reunindo os benefícios da inoculação e da coinoculação da soja, somente em 2024, a economia estimada, ao dispensar o uso de fertilizantes nitrogenados, foi estimada em 25 bilhões de dólares. Além do benefício econômico, o uso dessas bactérias ajudou a mitigar, em 2024, a emissão de mais de 230 milhões de toneladas de CO₂ equivalentes para a atmosfera.
Associado aos trabalhos com soja, a pesquisadora também coordena pesquisas que culminaram com o lançamento de outras tecnologias: autorização/recomendação de bactérias (rizóbios) e coinoculação para a cultura do feijoeiro, Azospirillum brasilense para as culturas do milho e do trigo e de pastagens com braquiárias. Ainda em relação às gramíneas, em 2021, a equipe da pesquisadora lançou uma tecnologia que permite a redução de 25% na fertilização nitrogenada de cobertura em milho por meio da inoculação com Azospirillum brasilense, gerando benefícios econômicos significativos para os agricultores e impactos ambientais positivos para o país.
Trajetória profissional e reconhecimentos
Nascida em 1958, em São Paulo, e criada em Itapetininga (SP), Mariangela conta que desde a infância teve curiosidade por conhecer o que envolve os aspectos relacionados à terra, à água e ao ar. Sua busca por conhecimento e seu espírito científico, a levaram a cursar Engenharia Agronômica (Esalq/USP), mestrado em Solos e Nutrição de Plantas (Esalq/USP), doutorado em Ciência do Solo (UFRRJ). Mariangela conta que cursou o doutorado na UFRRJ, enquanto realizava a tese na Embrapa, a convite da pesquisadora Johanna Döbereiner, cientista que revolucionou a agricultura tropical ao descobrir e aplicar a fixação biológica de nitrogênio (FBN) em culturas agrícolas.
Em 1982, tornou-se pesquisadora da Embrapa: inicialmente na Embrapa Agrobiologia (Seropédica, RJ) e, desde 1991, na Embrapa Soja (Londrina, PR). Mariangela acumula ainda três pós-doutorados em universidades nos Estados Unidos e Espanha (Cornell University, University of California-Davis e Universidade de Sevilla). A cientista possui mais de 500 publicações científicas, documentos técnicos, livros e capítulos de livros. Também já orientou mais de 200 alunos de graduação e pós-graduação. Ao refletir sobre sua carreira, Mariangela coloca como características determinantes o trabalho com coerência, persistência e resiliência. “Sempre acreditei na vida no solo, nos microrganismos restaurando a fertilidade, em uma agricultura altamente produtiva que não prejudica o meio ambiente. Nunca me desviei nem um milímetro do que eu acreditava. Essa coerência — tanto na pesquisa quanto na minha postura — trouxe credibilidade científica e fortes conexões com o setor agrícola”, ressalta a pesquisadora.
Mariangela é comendadora da Ordem Nacional do Mérito Científico e membro titular da Academia Brasileira de Ciências, da Academia Brasileira de Ciência Agronômica e da Academia Mundial de Ciências. É professora e orientadora da pós-graduação em Microbiologia e em Biotecnologia na Universidade Estadual de Londrina. Atua também na Sociedade Brasileira de Ciência do Solo e na Sociedade Brasileira de Microbiologia.
Desde 2020 Mariangela está classificada entre os 100 mil cientistas mais influentes no mundo, de acordo com o estudo da Universidade de Stanford (EUA). Em 2022, a pesquisadora ocupou a primeira posição brasileira, confirmada em 2025, em Fitotecnia e Agronomia (Plant Science and Agronomy) e em Microbiologia, em lista publicada pelo Research.com, um site que oferece dados sobre contribuições científicas em nível mundial.
Já recebeu várias premiações pela sustentabilidade em agricultura, como o Frederico Menezes, Lenovo-Academia Mundial de Ciências, da Frente Parlamentar Agropecuária e da Fundação Bunge. Em 2025, recebeu o Prêmio Mulheres e Ciência, promovido pelo Conselho Nacional de Desenvolvimento Científico e Tecnológico (CNPq), em parceria com o Ministério das Mulheres, o British Council e o Banco de Desenvolvimento da América Latina e Caribe. Em 2025, a Fundação World Food Prize concedeu o Prêmio Mundial da Alimentação (WFP), conhecido como o “Nobel da Agricultura” à pesquisadora Mariangela Hungria.


